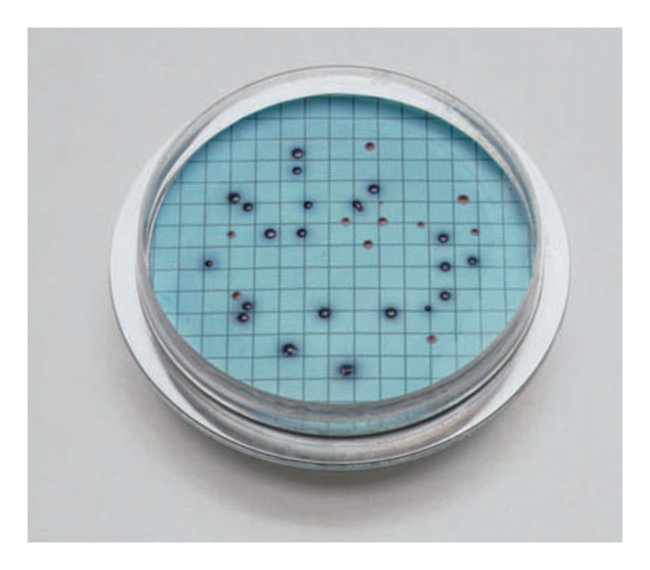

M-Coliblue24™ Broth Culture Media, Pack Of 50
$ 391.42
|
|
Details:
Simultaneously detects total coliforms and E. coli in water and beverages using standard membrane filtration equipment
Additional Information
| SKU | 10531272 |
|---|---|
| UOM | 1 Pc |
| UNSPSC | 41122100 |
| Manufacturer Part Number | M00PMCB24 |
